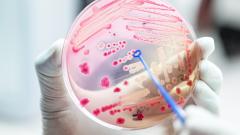
Изобретён антибиотик, к которому бактерии не способны подстроиться

Новости
Предыдущие исследования показывали, что вирус может передаваться от человека к человеку, даже если у носителя нет симптомов.
За этот же день в столице выписано 5390 пациентов.
По мере того, как в США ослабляют карантин, случаев заболевания COVID-19 вновь становится больше.
В университете Калифорнии подсчитали, как изменилось бы количество заражений коронавирусом без введения жёсткого карантина.
Академик РАН Виталий Зверев рассказал, изменится ли активность коронавируса в жаркую и солнечную погоду.
С 9 июня Москва возвращается к нормальной жизни.
И в опытах на мышах этот путь удалось перекрыть.
С 08 июня телеканал «Доктор» предлагает с пользой для своего здоровья провести время дома и приглашает зрителей присоединиться к тренировкам, разработанным Минздравом РФ и ВОЗ.
Но лишь в течение пяти дней, с 15 по 19 июня.
Испанский художник Хуан Луцена написал картину, посвящённую жертвам COVID-19.
Коронавирус распространяется в основном при собрании больших групп людей в закрытом помещении, заявили учёные.
В мировой статистике произошли существенные изменения в десятке стран с максимальным числом заболевших.
19-летнюю Светлану Анурьеву представят к посмертной награде за помощь односельчанам.
Исследователи обнаружили, что облысение является серьёзным фактором риска при коронавирусной инфекции.
Русскоязычный реаниматолог Евгений Пинелис, который на протяжении последних месяцев вел хронику развития пандемии коронавирусной инфекции в Нью-Йорке, констатировал, что в его больнице пациентов с COVID-19 почти не осталось.
Голландские учёные выяснили, что витамин К может существенно облегчить течение коронавирусной инфекции.
Опасно ли пользоваться кондиционерами и вентиляторами в офисе и дома, рассказал вирусолог Александр Лукашев.
Представитель ВОЗ Маргарет Харрис заявила, что «в настоящее время Россия демонстрирует плато» по COVID-19.
Коронавирусная инфекция меньше повлияла на людей из высокогорных районов.
Нарушения свёртываемости крови теперь можно будет выявлять быстро и точно.
В словах известной телеведущей оказалось много странного.
Миллиардер, бизнесмен и филантроп Билл Гейтс рассказал, почему его беспокоит конспирологическая теория о чипировании людей через прививку от коронавируса.
Ведущие мировые журналы по медицине опубликовали материалы исследований, проведённых на основе данных крошечной американской компании, которые ничем не подтверждаются.
Если бы Москва была страной, она заняла бы 9-е место в мире по этому показателю.
США подарили России ещё 150 аппаратов ИВЛ.
Учёные обнаружили в коронавирусе вставку, идентичную части человеческого белка.
Синтетические эритроциты способны не только переносить кислород, но и доставлять лекарства и выделять опасные токсины.
Открытие американских учёных способно уничтожать даже бактерии, устойчивые ко всем известным антибиотикам.
Специалист Минздрава Екатерина Каракулина назвала самые распространённые виды рака в стране.
Оценку эффективности лечения донорской плазмой пациентов с коронавирусной инфекцией дало новое исследование китайских учёных.